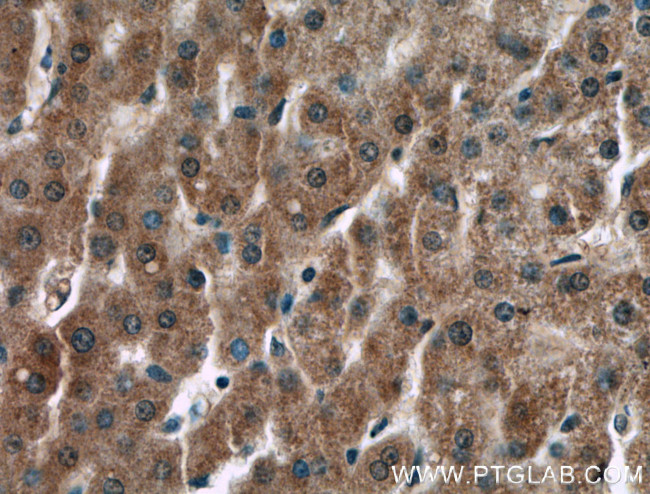
F2 Antibody in Immunohistochemistry (Paraffin) (IHC (P))

Search
Proteintech
F2 Monoclonal Antibody (1E12A8)
{{$productOrderCtrl.translations['antibody.pdp.commerceCard.promotion.promotions']}}
{{$productOrderCtrl.translations['antibody.pdp.commerceCard.promotion.viewpromo']}}
{{$productOrderCtrl.translations['antibody.pdp.commerceCard.promotion.promocode']}}: {{promo.promoCode}} {{promo.promoTitle}} {{promo.promoDescription}}. {{$productOrderCtrl.translations['antibody.pdp.commerceCard.promotion.learnmore']}}
产品信息
66509-1-IG
种属反应
宿主/亚型
分类
类型
克隆号
抗原
偶联物
形式
浓度
纯化类型
保存液
内含物
保存条件
运输条件
产品详细信息
Immunogen sequence: WCYVAGKPG DFGYCDLNYC EEAVEEETGD GLDEDSDRAI EGRTATSEYQ TFFNPRTFGS GEADCGLRPL FEKKSLEDKT ERELLESYID GRIVEGSDAE IGMSPWQVML FRKSPQELLC GASLISDRWV LTAAHCLLYP PWDKNFTEND LLVRIGKHSR TRYERNIEKI SMLEKIYIHP RYNWRENLDR DIALMKLKKP VAFSDYIHPV CLPDRETAAS LLQAGYKGRV TGWGNLKETW TANVGKGQPS VLQVVNLPIV ERPVCKDSTR IRITDNMFCA GYKPDEGKRG DACEGDSGGP FVMKSPFNNR WYQMGIVSWG EGCDRDGKYG FYTHVFRLKK WIQKVIDQFG E (273-622 aa encoded by BC051332)
靶标信息
Prothrombin or Coagulation factor II, is proteolytically cleaved to form thrombin in the first step of the coagulation cascade which ultimately results in the stemming of blood loss. F2 also plays a role in maintaining vascular integrity during development and postnatal life. Mutations in F2 leads to various forms of thrombosis and dysprothrombinemia.
仅用于科研。不用于诊断过程。未经明确授权不得转售。
篇参考文献 (0)
生物信息学
蛋白别名: Coagulation factor II; coagulation factor II (thrombin); prepro-coagulation factor II; Prothrombin; prothrombin B-chain; serine protease
基因别名: F2; PT; RPRGL2; THPH1
UniProt ID: (Human) P00734
Entrez Gene ID: (Human) 2147